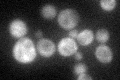
YMR250W
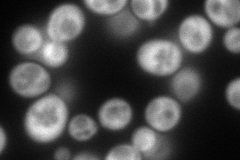
YMR250W
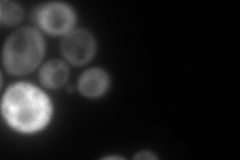
YMR250W

View description
Glutamate decarboxylase, converts glutamate into gamma-aminobutyric acid (GABA) during glutamate catabolism; involved in response to oxidative stress
Localization:
Intensity:
Fold change:
Significance:
-
C’ GFP library in SD
cytosol45.08 -
N' NOP1pr-GFP in SD
cytosol218.375 -
N' TEF2pr-mCherry in SD
cytosol207.891 -
N' NATIVEpr-GFP in SD

cytosol42.9743 -
N' TEF2pr-VC and Cyto-VN in SD

cytosol57.5329 -
C’ GFP library in SD+DTT

cytosol56.231.24No -
C’ GFP library in SD+H2O2

cytosol50.61.12No -
C’ GFP library in Starvation Media

cytosol125.612.78Yes -
C’ GFP library on the background of Pup2-DaMP

cytosol -
C’ GFP library on the background of CCT mutant

cytosol47.71031.05823No
